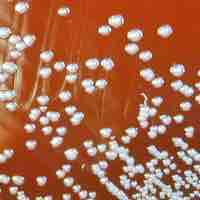

Chapter 8
Microbial Evolution, Phylogeny, and Diversity
By Boundless

Evidence for evolution has been obtained through fossil records, embryology, geography, and molecular biology.

Key elements were needed for early life to start on earth.

The question of how simple organic molecules formed a protocell is largely unanswered.

Mars, the fourth planet from the Sun, is currently undergoing a great deal of investigation concerning its capacity for maintaining life.

A biosignature, a substance that provides scientific evidence of past or present life, is present in the form of fog on the planet Mars.

Terraforming Mars is the hypothetical idea that Mars could be altered in such a way to sustain human and terrestrial life forms.

Europa, one of Jupiter's four moons, is covered by a layer of ice/water and scientists have multiple hypotheses to explain its structure.

Natural selection can only occur in the presence of genetic variation; environmental conditions determine which traits are selected.

Similar traits can be either homologous structures that share an embryonic origin or analogous structures that share a function.

Taxanomic classification divides species in a hierarchical system beginning with a domain and ending with a single species.

Bacterial taxonomy is the rank-based classification of bacteria.
Diagnosis of infectious disease sometimes involves identifying an infectious agent either directly or indirectly.

The number of species of bacteria and archaea is surprisingly small, despite their early evolution, genetic, and ecological diversity.

Nomenclature is the set of rules and conventions that govern the names of taxa.

Microorganisms can be classified on the basis of cell structure, cellular metabolism, or on differences in cell components.

Prokaryotic organisms were the first living things on earth and still inhabit every environment, no matter how extreme.

The molecular approach to microbial phylogenetic analysis revolutionized our thinking about evolution in the microbial world.

In medicine, microorganisms are identified by morphology, physiology, and other attributes; in ecology by habitat, energy, and carbon source.

The Proteobacteria are a major group (phylum) of bacteria.

Alphaproteobacteria is a class of Proteobacteria; like all Proteobacteria, they are Gram-negative.
Betaproteobacteria is a class of Proteobacteria that are all Gram-negative.

The two main groups of morphologically unusual proteobacteria include spirillum and prosthecate bacteria.

Gammaproteobacteria is a class of several medically, ecologically and scientifically important groups of bacteria.

Deltaproteobacteria is a class of Proteobacteria that are Gram-negative.

Epsilonproteobacteria is a class of Proteobacteria that are Gram-negative.

Actinobacteria are Gram-positive bacteria with high guanine and cytosine content in their DNA and can be terrestrial or aquatic.
The Firmicutes are a phylum of bacteria, most of which have Gram-positive cell wall structure and some of which do not produce spores.

The Firmicutes are a phylum of bacteria, most of which have Gram-positive cell wall structure and some of which can form endospores.
Actinobacteria are a group of Gram-positive bacteria with high guanine and cytosine content in their DNA.

The cyanobacteria, also known as blue-green bacteria, are a phylum of bacteria that obtain their energy through photosynthesis.

Some groups of bacteria can capture light energy and convert it to ATP without the production of oxygen through anoxygenic photosynthesis.

Picoplankton is the fraction of plankton which can be photosynthetic or heterotrophic.

Chlamydiae are a bacterial phylum and class whose members are obligate intracellular pathogens.

Planctomycetes are a phylum of aquatic bacteria and are found in samples of brackish, marine, and fresh water.

Verrucomicrobia is a recently described phylum of bacteria which is part of the PVC superphylum.

Bacteroides and Flavobacterium are both Gram-negative bacteria that can be either motile or non-motile.

Acidobacteria are a newly formed phylum of bacteria that are physiologically diverse and abundant in soil environments.

Cytophaga are a type of bacteria characterized as Gram-negative, rod shaped bacteria that utilize a gliding mechanism for locomotion.

Bacteria categorized under the Phylum Bacteroidetes and Phlyum Chlorobi are closely related base on comparative genomic analysis.

Fusobacterium are anaerobic, non-spore forming, gram-negative bacteria that are associated with periodontal disease and Lemierre's syndrome.
Spirochaetes are characterized by the presence of a double-membrane and long, spiral-shaped cells that are chemoheterotrophic.

Along with Thermotogae, members of Aquificae are thermophilic eubacteria.

The Deinococcus-Thermus are a small group of bacteria composed of cocci highly resistant to environmental hazards.

Chloroflexus are Gram-negative filamentous anoxygenic phototrophic organisms that utilize type II photosynthetic reaction centers.

Nitrospirae is a phylum of bacteria; some nitrospirae species perform important functions in the nitrogen cycle.

The Aquificae phylum is a diverse collection of bacteria found in harsh environments: hot springs, sulfur pools, and thermal ocean vents.
Crenarchaeota exist in a wide range of habitats and exhibit a great variety of chemical reactions in their metabolism.

A hyperthermophile thrives at relatively high temperatures and can be found in geothermally heated regions of the Earth.

Hyperthermophiles live in dark regions of the oceans and use chemosynthesis to produce biomass from single carbon molecules.

Nonthermophilic Crenarchaeota can be extreme halophiles living in highly salty environments.

Psychrophiles crenarchaeotes are extremophilic organisms that are capable of growth and reproduction in cold temperatures.
There are over 50 described species of methanogens, sharing over 30 signature proteins.

Halophiles are extremophiles that thrive in environments with very high concentrations of salt.

Methanogens are an important group of microoraganisms that produce methane as a metabolic byproduct under anaerobic conditions.
There are many classes in the phylum Euryarchaeota, many of which are extremophiles.
Archaeoglobus is a genus of Euryarchaeota found in high-temperature oil fields.

Nanoarchaeum equitans is a species of marine Archaea discovered in a hydrothermal vent off the coast of Iceland.

A hyperthermophile is an organism that thrives in extremely hot environments, from 60 degrees C (140 degrees F) and up.

Eukaryotes are very diverse in phylogenic terms, the common feature being a membrane bound nucleus.

Until more recent work, the historical view of eukaryotes has been anthropomorphic.

Opisthokonts include the animal and fungus kingdoms.

Genome fusion occurs during endosymbiosis, which is the mechanism proposed as responsible for the first eukaryotic cells.

Protists are an incredibly diverse set of eukaryotes of various sizes, cell structures, metabolisms, and methods of motility.

There are many new species to be discovered, including eukaryotic species.

Fungi, latin for mushroom, are eukaryotes which are responsible for decomposition and nutrient cycling through the environment.

From crop and food spoilage to severe infections in animal species, fungal parasites and pathogens are wide spread and difficult to treat.

Fungi are the major decomposers of nature; they break down organic matter which would otherwise not be recycled.

Chytrids are the most primitive group of fungi and the only group that possess gametes with flagella.

Zygomycota, a small group in the fungi kingdom, can reproduce asexually or sexually, in a process called conjugation.
Glomeromycetes are an important group of fungi that live in close symbiotic association with the roots of trees and plants.

Most fungi belong to the Phylum Ascomycota, which uniquely forms of an ascus, a sac-like structure that contains haploid ascospores.

The basidiomycota are mushroom-producing fungi with developing, club-shaped fruiting bodies called basidia on the gills under its cap.

Protists are eukaryotes that first appeared approximately 2 billion years ago with the rise of atmospheric oxygen levels.

Excavata, defined by a feeding groove that is "excavated" from one side, includes Diplomonads, Parabasalids and Euglenozoans.

Alveolates are defined by the presence of an alveolus beneath the cell membrane and include dinoflagellates, apicomplexans and ciliates.

Stramenophiles include photosynthetic marine algae and heterotrophic protists such as diatoms, brown and golden algae, and oomycetes.

Rhizaria are a supergroup of protists, typically amoebas, that are characterized by the presence of needle-like pseudopodia.

Amoebozoa are a type of protist that is characterized by the presence of pseudopodia which they use for locomotion and feeding.

Helminths are parasitic worms that live and feed on living hosts to receive nourishment and protection which results in illness of the host.

Helminths, or parasitic worms, are eukaryotic parasites characterized by their ability to feed and live on living hosts.

Parasitic worms, distributed worldwide, are hypothesized to have importance in immune system regulation.

Arthropods are capable of functioning as vectors by transmitting diseases.